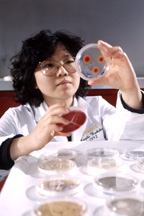

Purdue News
Purdue News
 Purdue News
Purdue News
|
Since the 1930s, the farm labor force has declined by about three-fourths, and cropland in use has decreased by 10 percent. The USDA index of the use of machinery and mechanical power almost doubled from World War II until the late 1970s, but it too declined -- by about 30 percent -- in the 1980s.
"Since World War II, farm labor productivity has increased over sevenfold," says Marshall Martin, professor and associate head of the Department of Agricultural Economics at Purdue University. "In contrast, labor productivity in the nonfarm business sector during the same time period has increased only 2.6 fold."
Martin lists four major reasons for these farm productivity increases:
"Excluding the drought years, average U.S. corn yields have doubled in the last 30 years, from about 60 bushels per acre in the early 1960s to more than 120 bushels in the 1990s," says Martin. "That's about two bushels per year."
In fact, U.S. corn yields have doubled about every 30 years in this century, according to Ralph Gann, USDA's Agricultural Statistics Service state statistician for Indiana.
Howard Doster, a Purdue Extension farm management specialist, notes that it once took about one hour of farm labor to produce a bushel of corn. "By the 1990s, the average American farmer produced a bushel of corn in less than one minute of labor," he says.
That's based on 40 bushels per acre in the late 1930s and an estimate of about 40 hours of labor to produce one acre of corn compared to 120 bushels per acre today with about two hours of labor.
U.S. wheat yields also doubled in the last 30 years from about 19 bushels to 38 bushels per acre.
Also excluding drought years, U.S. soybean yields have increased about 40 percent, from 24 bushels to 34 bushels per acre in the same time period.
Increases, while not as large, have also been significant in the livestock sector.
For example, in 1965, the average carcass weight produced per cow in inventory was 360 pounds (including both beef and dairy). Today, that figure has climbed to 569 pounds, largely because of increased weaning weights in cattle.
In addition to increasing productivity, today's producers are better meeting consumer's demands. For example, consumers want leaner meat. Compared to the hog of the 1950s, today's model has slimmed down to 50 percent less fat, according to the National Pork Producers Council.
Because technology drove many of the productivity increases, one report in the USDA's Agricultural Outlook noted that U.S. agriculture has transformed from a resource-based to an information- and science-based industry. In other words, the big gains are not necessarily from adding more labor and land, but from using technology.
This has two implications for agriculture in the future, Martin says: Education will continue to play an even more important role in farming, and agricultural research will be vital to the development of new technology to keep farming competitive.
Where will the new technology be focused in the near-term? "Micro developments ushered in a new era for U.S. agriculture," Martin says. Computers with microchips help farmers apply seed and fertilizers with far greater accuracy, monitor production, and help with economic analysis.
The next big wave of technology, Martin says, will be in molecular biology, which is providing researchers with a better understanding of the growth and behavior of plants and animals at the cellular level.
How we use these technologies depends on consumer choices, government policies, general economic trends and international policies.
Phil Paarlberg, associate professor of agricultural economics at Purdue, says: "One of the factors affecting continued use of technology worldwide will be people's attitudes. In the '50s we looked mostly at the positives of technology, and swept the negatives away. That is not the case today, because we often focus on the negative consequences of technology. Technology is not socially neutral. It has good and bad effects that need to be managed if they are to be applied."
How those decisions are made in the next 30 years will determine whether or not the average corn yield in the U.S. will reach 250 bushels per acre by 2027.
Sources: Marshall Martin (765) 494-4268; e-mail, martin@agecon.purdue.edu
Howard Doster (765) 494-4250; e-mail, doster@agecon.purdue.edu
Ralph Gann (765) 494-8371
Phil Paarlberg (765) 494-4251; e-mail, paarlberg@agecon.purdue.edu
Writer: Steve Cain (765) 494-8410; e-mail, cain@ecn.purdue.edu
Purdue News Service: (765) 494-2096; e-mail, purduenews@purdue.edu
Photo Caption
Color photo, electronic transmission, and Web and ftp download available. Photo ID:
Martin/Productivity
Download here